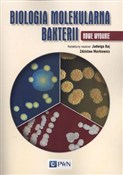
Książka : Biologia m... - Opracowanie Zbiorowe

Filtruj według ceny
Filtrowanie według atrybutów
- Dostępność
- ukryj niedostępne
- Wysyłka
- szybka wysyłka
Biologia. Przyroda
|
€7,72
|
Atlas biologii Liceum i technikum [Miękka]
|
€15,51
|
Hodowla pszczół [Miękka]
|
€8,73
|
Dzień wszystkiego [Miękka]
|
€20,55
|
Biologia systemów [Miękka]
|
€11,38
|
Parki narodowe Symbole polskiej przyrody [Twarda]
Zapraszamy do zakupu produktów z tej kategorii.